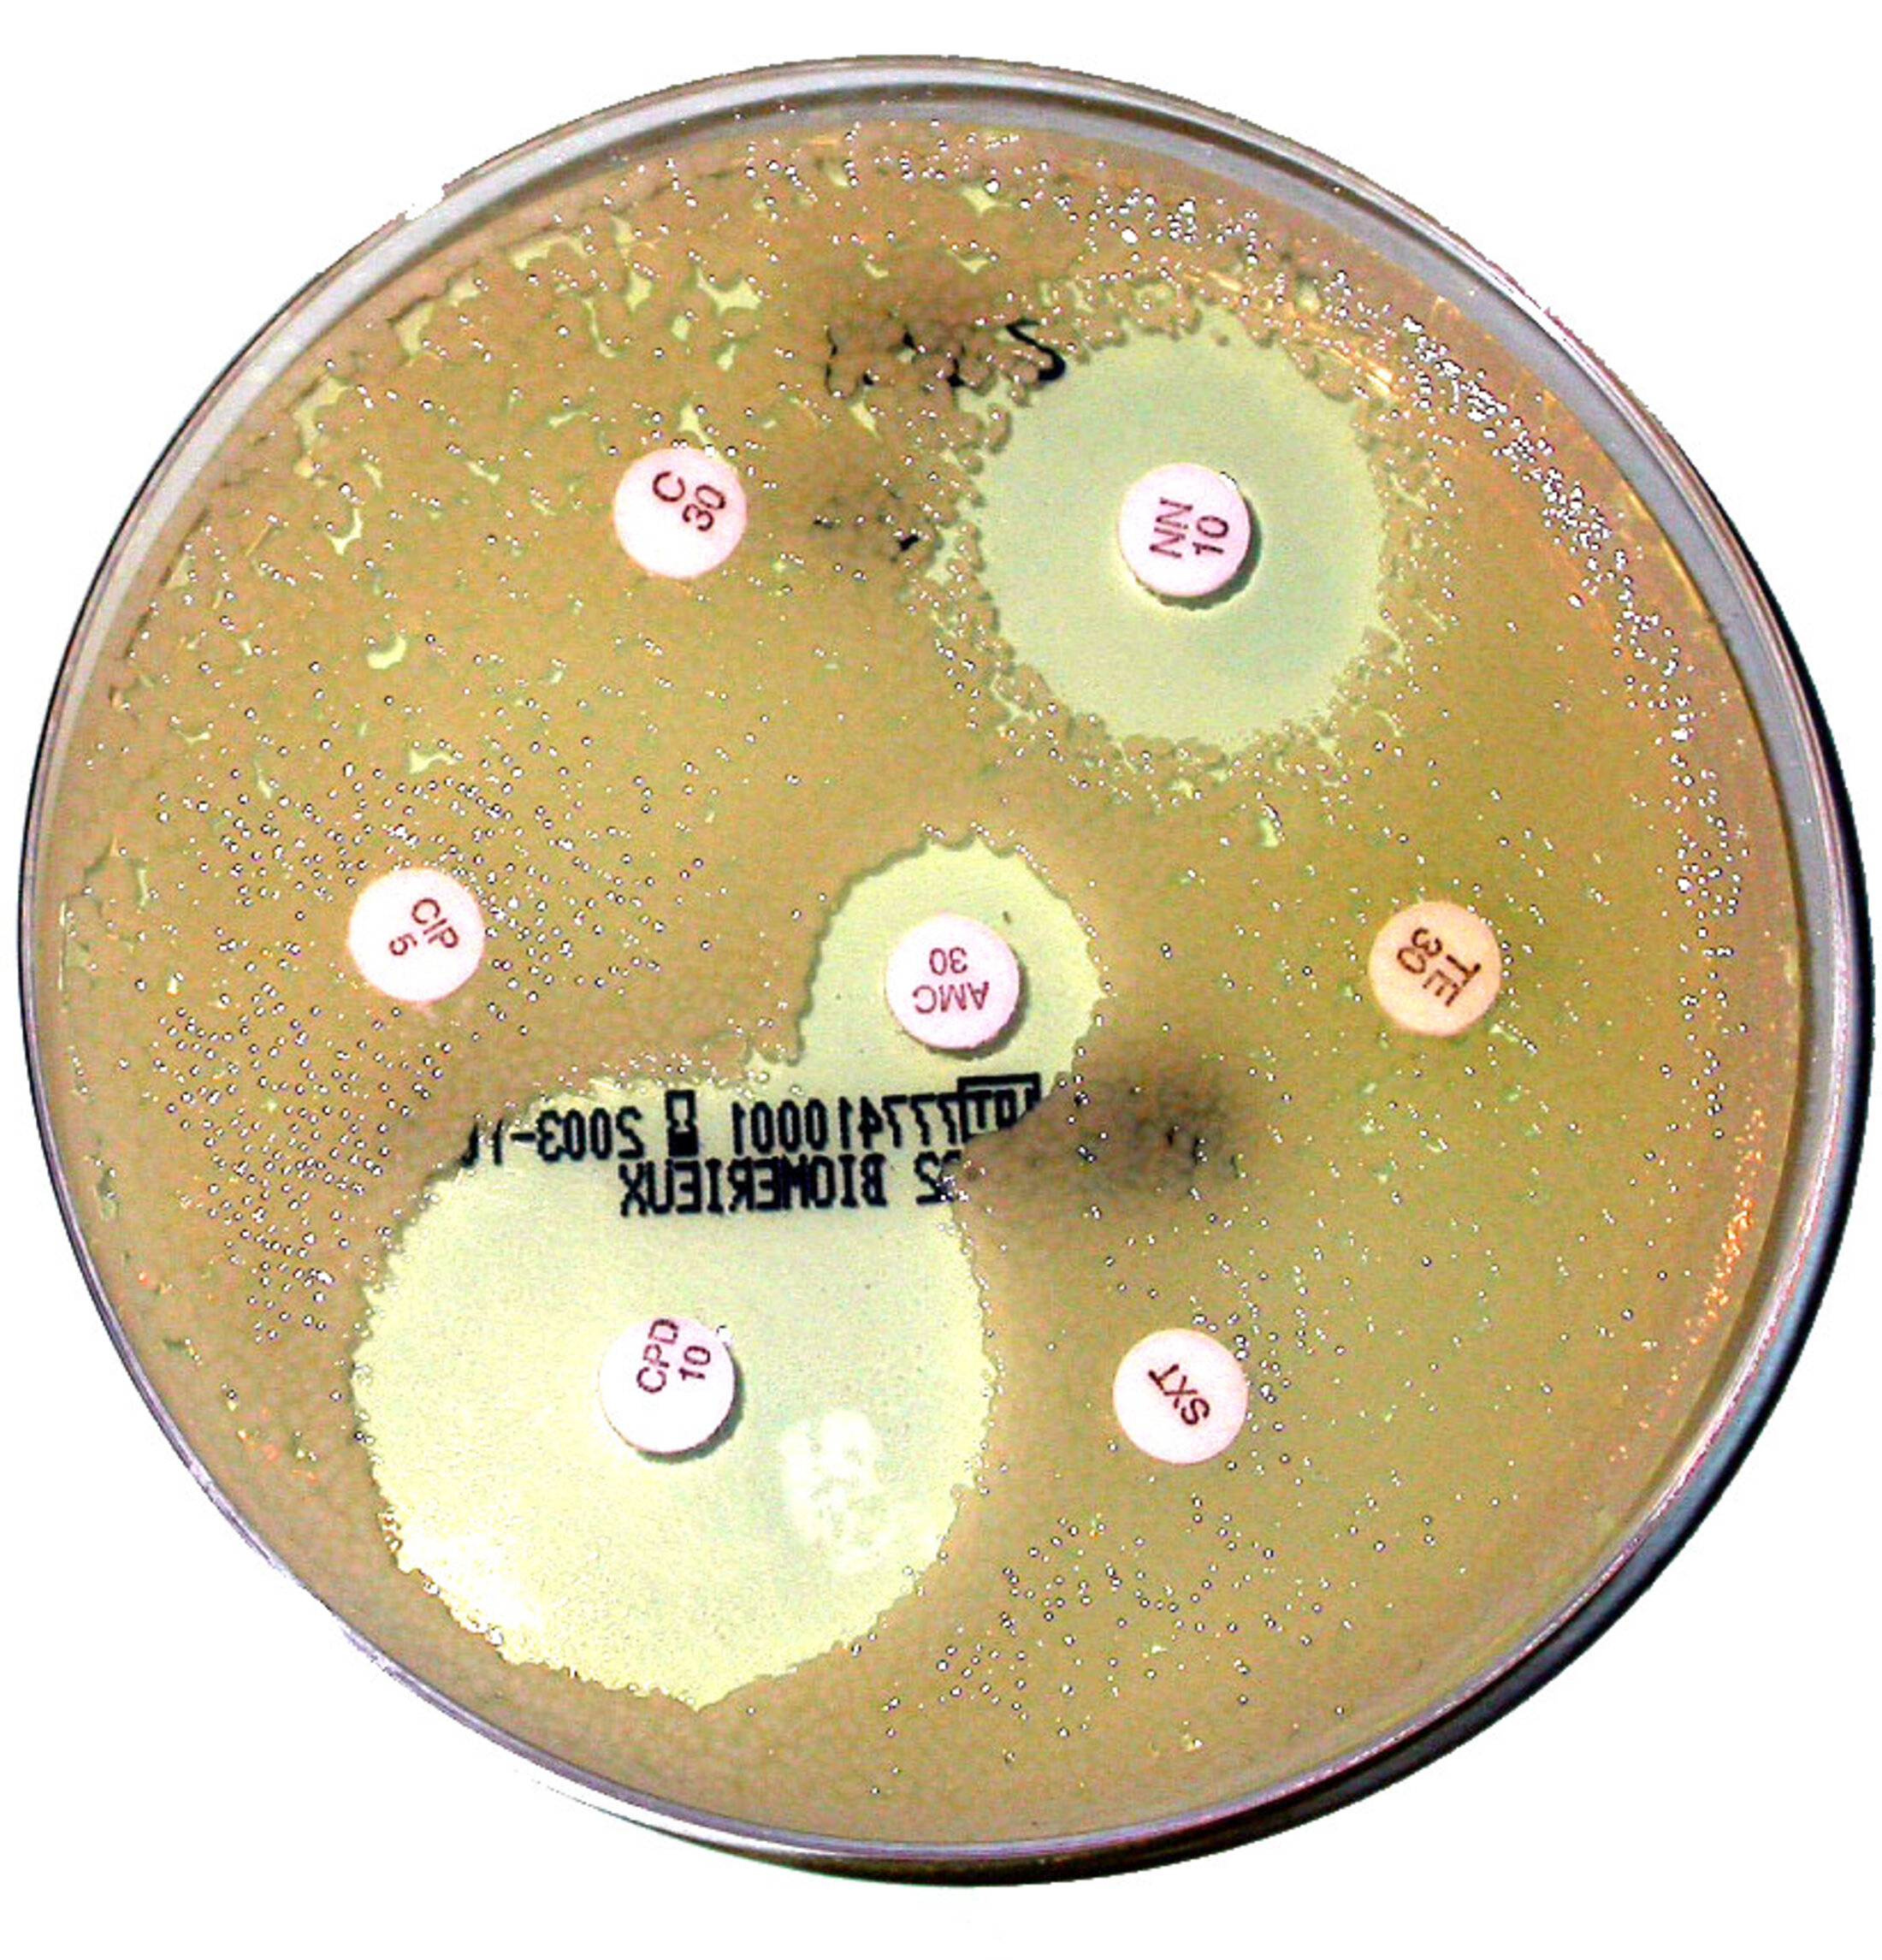

Agrandissement : Illustration 1
... alors il convient de s'interroger.
Dénigrer le travail de l'étranger
Reprenons le rapport 2016 de l'ANSM sur la phagothérapie.
Nous y lisons : "... les limites de la documentation notamment sur des aspects pharmacologiques, de modalités d’administration occasionnent des incertitudes et des questions." page 10
Limites de la documentation ?
Qui, en France, a lu les milliers de page de publications académiques en anglais, en russe et dans d'autres langues ?
Un siècle de recherche et de pratique de la phagothérapie ça laisse quelques traces.
Mais non ! C'est tellement mieux 1. De décider qu'il faut faire d'autres recherches qui mettrons des années avant de devenir des publications puis des pratiques 2. Pendant ce temps de laisser mourir les patients !
Au cas où le lecteur n'aurait pas compris, on répète dans le dit rapport : " Il a été soulevé la faiblesse de documentation sur des modalités d’utilisation des phages, ..."
La documentation a été faite à l'étranger donc elle est "faible".
Même si l'on trouve en France et en français la description des modalités d'utilisation des phages !!!
Le rapport devient grandiose : "Ce board rendra un avis à l’ANSM en s’appuyant sur les données de la littérature, ..." p. 13
La documentation est limitée et faible mais elle permet quand même de prendre des décisions pour l'utilisations de phages pour un patient !!!
Soit le board est constitué de génies qui peuvent prendre des décisions cliniques sans littérature, soit la littérature existe et a une qualité suffisante !!!
Il y a tout ce qu'il faut pour créer un diplôme de phagothérapeute
Imaginons une sage décision de nos Ministres de la santé et de l'enseignement supérieur : créer un diplôme.
Les médecins, pharmaciens et chercheurs en science de l'homme qui monteraient ce diplôme feraient nécessairement un inventaire de la littérature académique disponible.
On traduirait quelques textes actuellement en anglais, en russe, etc.
On réaliserait ainsi que cette littérature est largement suffisante.
On voit que les choses doivent se faire à l'inverse des réflexes automatiques :
- D'abord on décide de faire le diplôme.
- En le faisant, on évalue vraiment la qualité de la littérature académique.
C'est pas moi c'est l'autre
Qui va lancer la machine ?
La Ministre de la Santé ou la Ministre de l'enseignement supérieur et de la recherche ? Agnès ou Frédérique ?
Côté santé, l'ANSM dit "on n'a pas assez de documentation".
Côté recherche, on met 40 millions d'euros pour approfondir la recherche.
Or, il y a 500 mille pages de publications sur les phages et on va en produire encore.
Qui va se réveiller et dire : "D'abord on traduit et on lit !"
Pour informer une alerte, il faut traduire et lire
Le lanceur d'alerte n'a pas 40 millions d'euros ...
Le lanceur d'alerte est pressé pour sauver des vies humaines.
Il doit faire avec la littérature qui existe !
Exemple : En ce moment traduction et lecture du rapport fondamental sur l'antibiorésistance, le rapport O'Neill. (1)
Pourquoi est-ce le lanceur d'alerte qui doit faire cette traduction qui devrait être :
1. Dans les références bibliographiques du rapport de l'ANSM (2)
2. Accessible en ligne
Notes
(1) Le lecteur peut suivre en direct ce travail. Cela fait maintenant 20 ans que nous faisons découvrir de cette manière le travail du chercheur, du didacticien, du lanceur d'alerte, etc. Principe : un document en cours de rédaction est disponible en temps réel en ligne - depuis le mémoire de thèse jusqu'à l'article de vulgarisation.
(2) Dans le rapport O'Neill il y a 117 références à des documents, dans le document de l'ANSM il y en a Zéro !



